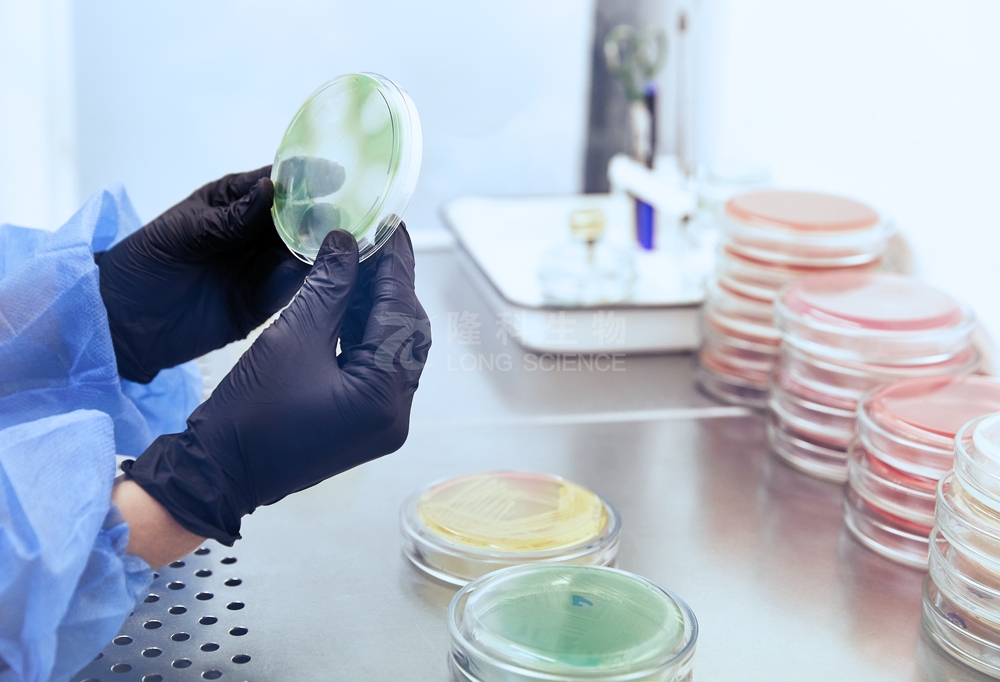

电话:17657166935
QQ:2301757537
地址:山东省青岛市城阳区上马街道河东路上马科技企业加速器202室
邮箱:longkesci@163.com
最低抑菌浓度(MIC)
最低抑菌浓度(MIC)是指在体外培养条件下,抗菌药物能够抑制某种微生物生长的最低浓度。它是衡量抗菌药物抗菌活性的重要指标,对于指导临床用药、评估新药疗效等具有重要意义。
MIC 的测定方法有多种,常见的有肉汤稀释法和琼脂稀释法。肉汤稀释法是将抗菌药物在液体培养基中进行系列稀释,然后接种待测微生物,经过一定时间的培养后,观察微生物的生长情况,以无肉眼可见生长的最低药物浓度作为 MIC。琼脂稀释法则是将抗菌药物与琼脂培养基混合,制成含不同浓度药物的平板,再接种待测微生物,培养后观察平板上微生物的生长情况,以无菌落生长的最低药物浓度作为 MIC。
在测定过程中,需要严格控制培养条件,如温度、时间、pH 值等,以确保结果的准确性和重复性。同时,还需要设置阳性对照和阴性对照,阳性对照为不含抗菌药物的培养基接种待测微生物,以确保微生物能够正常生长;阴性对照为含抗菌药物的培养基不接种待测微生物,以排除培养基和药物本身对结果的干扰。
最低杀菌浓度(MBC)
最低杀菌浓度(MBC)是指在体外培养条件下,抗菌药物能够杀灭某种微生物的最低浓度。与 MIC 不同,MBC 反映的是抗菌药物的杀菌能力,而 MIC 反映的是抑菌能力。
MBC 的测定通常是在 MIC 测定的基础上进行的。对于肉汤稀释法测定 MIC 后的培养物,从无肉眼可见生长的各管中分别取一定量的培养物,接种到不含抗菌药物的琼脂平板上,经过培养后,观察平板上的菌落数。以能够杀灭 99.9% 以上微生物的最低药物浓度作为 MBC。
MIC 与 MBC 的联系与区别
MIC 和 MBC 都是衡量抗菌药物抗菌活性的指标,两者密切相关。一般来说,MBC 的值大于或等于 MIC。对于某些抗菌药物,MIC 和 MBC 的值较为接近,说明该药物不仅能抑制微生物生长,还能快速杀灭微生物;而对于另一些抗菌药物,MBC 可能比 MIC 大很多,表明该药物的抑菌作用较强,但杀菌作用较弱。
两者的主要区别在于,MIC 反映的是抗菌药物抑制微生物生长的能力,而 MBC 反映的是杀灭微生物的能力。在临床应用中,MIC 可用于指导抗菌药物的剂量选择,而 MBC 则有助于评估抗菌药物的临床疗效和预后。
总之,准确测定 MIC 和 MBC 对于深入了解抗菌药物的作用机制、合理使用抗菌药物以及开发新的抗菌药物都具有重要意义。在实际操作中,应根据具体情况选择合适的测定方法,并严格按照操作规程进行,以获得可靠的结果。